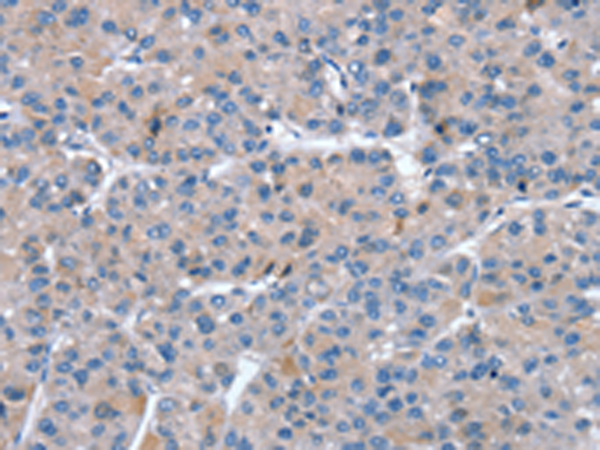

-
分类: 科研抗体货号: P08760别名: TID1; HCA57; hTID-1应用: IHC反应种属: Human, Mouse
-
分类: 科研抗体货号: P08752别名: SEMAF; SEMAI; SEMACL1; M-SEMA-F应用: IHC反应种属: Human, Mouse
-
分类: 科研抗体货号: P08772别名: CTLN2; CITRIN; ARALAR2应用: WB,IHC反应种属: Human, Mouse
-
分类: 科研抗体货号: P08794别名: MRT1; MY014应用: IHC反应种属: Human, Mouse, Rat
-
分类: 科研抗体货号: P08751别名: S4F; SEMAM; SEMAW; M-SEMA; PRO2353; m-Sema-M应用: IHC反应种属: Human, Mouse, Rat
-
分类: 科研抗体货号: P08771别名: DRS; ETX1; SRPX1; HEL-S-83p应用: WB,IHC反应种属: Human
-
分类: 科研抗体货号: P08793别名: HSAF001435应用: IHC反应种属: Human, Mouse, Rat
-
分类: 科研抗体货号: P08750别名: RP35; SEMB; SEMAB; CORD10应用: IHC反应种属: Human
-
分类: 科研抗体货号: P08770别名: APMCF1应用: WB,IHC反应种属: Human, Mouse, Rat
-
分类: 科研抗体货号: P08792别名: RDT; INI1; SNF5; Snr1; BAF47; MRD15; RTPS1; Sfh1p; hSNFS; SNF5L1; SWNTS1; PPP1R144应用: WB,IHC反应种属: Human, Mouse

鄂公网安备42018502007531号
鄂公网安备42018502007531号

